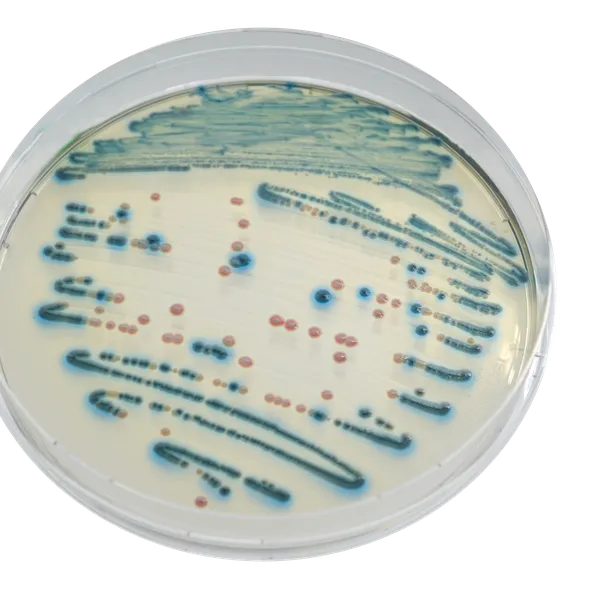
CHROMagar™ Enterobacteria

Hình thái khuẩn lạc

E. coli
màu xanh có hoặc không

Khác Enterobacteriaceae
màu hồng đến đỏ
Hiệu năng
Hiệu năng
«Enterobacteriaceae và vi khuẩn coliform trong họ này đại diện cho hai trong số các nhóm vi sinh vật chỉ thị phổ biến nhất được ngành công nghiệp thực phẩm sử dụng. Ở một số quốc gia, tùy thuộc vào quy định, ngành thực phẩm đã chuyển sang thử nghiệm Enterobacteriaceae.» ILSI Europe (Viện Khoa học Đời sống Quốc tế)
ISO 21528 chỉ định một phương pháp đếm Enterobacteriaceae, áp dụng cho sản phẩm dự kiến dùng cho tiêu thụ của con người, việc nuôi dưỡng động vật và mẫu môi trường sử dụng VRBG như môi trường nuôi cấy.
CHROMagar™, hợp tác với Tiến sĩ Marco Agosti, đã phát triển một môi trường nuôi cấy làm giảm đáng kể khối lượng công việc của phòng thí nghiệm so với VRBG truyền thống rất lao động tốn kém.
1. Dễ dàng phân biệt giữa E. coli và Enterobacteriaceae khác: Không giống như với VRBG, với CHROMagar™ Enterobacteria, bạn có thể dễ dàng phân biệt E. coli với phần còn lại của Enterobacteriaceae bằng màu sắc.
2. Dễ đọc: Khuẩn lạc có màu sắc đậm nét trên nền thạch trong suốt tạo điều kiện cho việc đọc kết quả, ngược lại với VRBG nơi nền mờ tạo ra ít độ tương phản.
3. Độ nhạy và độ đặc hiệu cao dẫn đến tỷ lệ phát hiện cao hơn của Enterobacteriaceae.
- Độ nhạy: 100 % *
- Độ đặc hiệu: 100 % *
* Độ đặc hiệu và độ nhạy từ nghiên cứu khoa học: "Xác nhận phương pháp thay thế để phân tích cho ISO 21528" Laboratoire de Tourraine, 2018.
Thành phần

Tài liệu kỹ thuật
Công bố khoa học
2018
Enumeration medium study for enterobacteria by enumeration of colonies in food products.
? Publication

Xem thêm